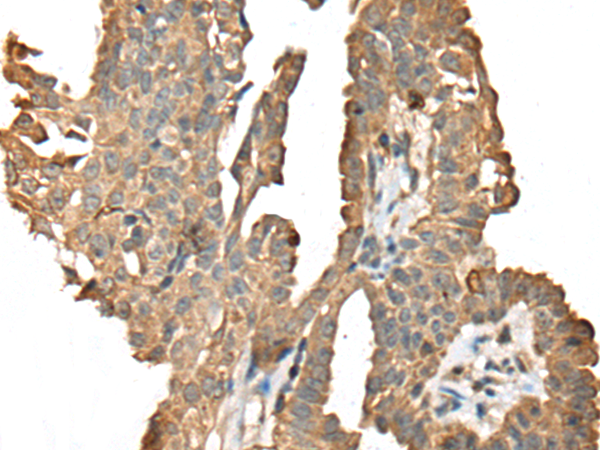

相關(guān)類別: 一抗
儲(chǔ) 存: 冷凍(-20℃)
宿 主: Rabbit
標(biāo) 記 物: Unconjugate
克隆類型: rabbit polyclonal
技術(shù)規(guī)格
|
Background: |
The protein encoded by this gene is T-cell receptor zeta, which together with T-cell receptor alpha/beta and gamma/delta heterodimers, and with CD3-gamma, -delta and -epsilon, forms the T-cell receptor-CD3 complex. The zeta chain plays an important role in coupling antigen recognition to several intracellular signal-transduction pathways. Low expression of the antigen results in impaired immune response. Two alternatively spliced transcript variants encoding distinct isoforms have been found for this gene. |
|
Applications: |
ELISA, IHC |
|
Name of antibody: |
CD247 |
|
Immunogen: |
Fusion protein of human CD247 |
|
Full name: |
CD247 molecule |
|
Synonyms: |
T3Z; CD3H; CD3Q; CD3Z; TCRZ; IMD25; CD3-ZETA |
|
SwissProt: |
P20963 |
|
ELISA Recommended dilution: |
5000-10000 |
|
IHC positive control: |
Human gastric cancer and human thyroid cancer |
|
IHC Recommend dilution: |
25-100 |

購(gòu)物車
幫助
021-54845833/15800441009
